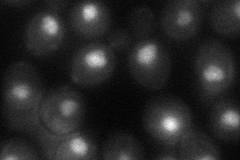
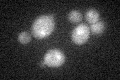

View description
Histone H3, core histone protein required for chromatin assembly, part of heterochromatin-mediated telomeric and HM silencing; one of two identical histone H3 proteins (see HHT2); regulated by acetylation, methylation, and phosphorylation
Localization:
Intensity:
Fold change:
Significance:
-
C’ GFP library in SD

below threshold17.69 -
N' NOP1pr-GFP in SD

nucleus122.605 -
N' TEF2pr-mCherry in SD

nucleus12.6315 -
N' NATIVEpr-GFP in SD

nucleus396.534 -
N' TEF2pr-VC and Cyto-VN in SD
nucleus42.0563 -
C’ GFP library in SD+DTT
cytosol15.860.89No -
C’ GFP library in SD+H2O2

cytosol16.40.92No -
C’ GFP library in Starvation Media

cytosol15.670.88No -
C’ GFP library on the background of Pup2-DaMP

below threshold -
C’ GFP library on the background of CCT mutant

below threshold15.84970.895396No
